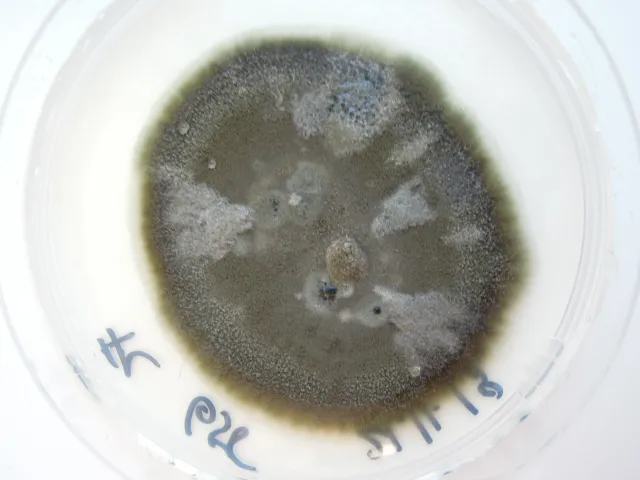

Navn og taksonomi
- Vitenskapelig navn:
- Davidiella tassiana (De Not.) Crous & U. Braun
- Synonymer:
- Mycosphaerella arthopyrenioides (Auersw.) Mig., Cladosporium graminum Corda, Mycosphaerella eriophila (Niessl) Mig., Mycosphaerella pachyasca (Rostr.) Vestergr., Mycosphaerella tassiana (De Not.) Johanson, Mycosphaerella trichophila (P. Karst.), Sphaerella eriophila Niessl, Sphaerella pachyasca Rostr., Sphaerella tassiana De Not., Sphaerella trichophila P. Karst., Sphaerella arthopyrenioides Auersw.
- Bokmål:
- Ingen
- Nynorsk:
- Ingen
- Nordsamisk/Davvisámegiella:
- Ingen
- Vitenskapelig navn ID:
- 66256
- Takson ID:
- 93457
Kategori
Fastlands-Norge
NE
Ikke vurdert
Registrerte funn i Norge
‐
Funn totalt
‐
Funn denne uken
‐
Funn i dag

Bilder
Siden siteres som
Artsdatabanken: Davidiella tassiana (De Not.) Crous & U. Braun
Hentet fra https://artsdatabanken.no/arter/takson/93457